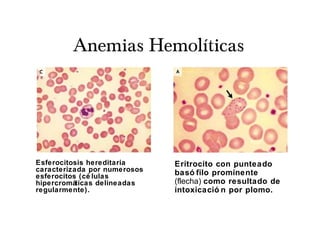
Anemias Hemolíticas
Esferocitosis hereditaria
caracterizada por numerosos
esferocitos (cé lulas
hipercromáticas delineadas
regularmente).
Eritrocito con punteado
basó filo prominente
(flecha) como resultado de
intoxicació n por plomo.

Este documento presenta información sobre el diagnóstico y clasificación de las anemias en pediatría. Resume los valores normales de hemoglobina, hematocrito y recuento de hematíes según la edad. Explica cómo clasificar las anemias según si hay disminución de la producción eritrocitaria o aumento de la destrucción de los eritrocitos. Además, detalla los estudios de laboratorio necesarios para diagnosticar diferentes tipos de anemia como la ferropénica, hemolítica o aplásica.